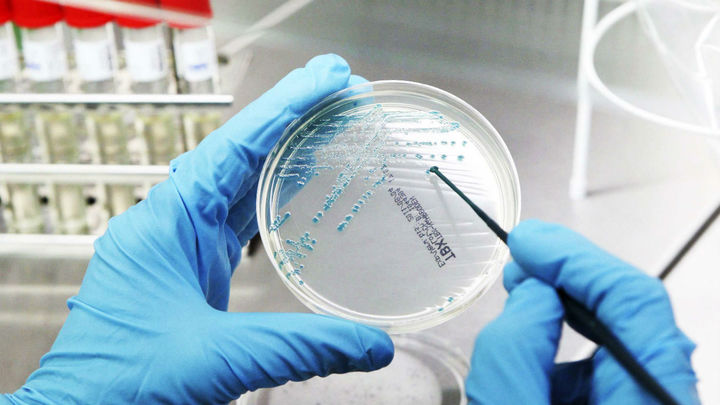
Numerosos actos este lunes con motivo del Día Mundial contra el Cáncer

- Compartir:
- Compartir en Facebook
- Compartir en Twitter
- Compartir en Whatsapp
- Compartir en Messenger
- Compartir en Messenger
Medio siglo en diez grandes hitos científicos españoles
- Potencia espacial a través del programa europeo de la ESA, conquistadores de la Antártida, descubridores de los orígenes de la humanidad o pioneros de la investigación
- Premios como el Princesa de Asturias e instituciones y organismos del CSIC han servido como motores públicos de promoción y financiación

Los últimos 50 años han marcado el despegue de un país que empezaba a abrirse al mundo y a desarrollarse económicamente a una democracia consolidada y la cuarta economía europea. Pero también, una potencia científica mundial.
Premios como el Princesa de Asturias e instituciones y organismos del CSIC han servido como motores públicos de promoción y financiación. Incluso contamos con un astronauta, Pedro Duque, al frente del ministerio de Ciencia e Innovación.
En un reciente informe de la Comisión Europea, se apunta a los factores que lastran el rendimiento de la I+D en España en mayor medida que en la media de la UE. Entre ellos, la falta de inversiones en I+D, el envejecimiento de la población, el desempleo o la baja productividad laboral.
No obstante, destaca el nivel de excelencia científica y el dinamismo internacional de los inventores españoles, con un elevado porcentaje de solicitudes internacionales de patente PCT en la que figuran conjuntamente con inventores extranjeros, muy por encima de la media de la UE. España supera la media de EEUU, Japón y Corea en cuanto a la actividad diseñadora, aunque por debajo de la media europea. La ciencia española continúa siendo un referente mundial y europeo.
Repasamos los grandes hitos de estas cinco décadas y también algunos de los más recientes.
Líderes en trasplantes de órganos

Público, universal y gratuito. Y líder mundial. Desde el año 1992, España es líder mundial en donaciones y en trasplantes realizados, tanto en el número total de intervenciones como en trasplantes por habitante.
Así lo certifican los 43,4 donantes por cada millón de habitantes, doblando el nivel de países cercanos. Tras el éxito de los primeros trasplantes españoles de José María Caralps (1983 y 1984), la Organización Nacional de Trasplantes fue un ejemplo en mediar con las familias tras la muerte de una persona.
En el año 2018, España registró un total de 2.241 donantes (48 donantes por millón de habitantes). Esta alta tasa de donación permitió que se realizara un total de 5.321 trasplantes de órganos sólidos. Sin embargo, el número de pacientes en lista de espera para recibir un trasplante aumentó en un 35% con respecto al año anterior. La Organización Nacional de Trasplantes, nacida en 1989, recibió el Premio Príncipe de Asturias en 2010.
Pioneros contra el cáncer
El Centro Nacional de Investigaciones Oncológicas (CNIO) es un referente de la investigación del cáncer en el mundo. Su primer director fue Mariano Barbacid. En la década de los años 80, sentó las bases moleculares del cáncer aislando el primer oncogén, RAS, responsable del desarrollo del 30% de los cánceres.
Ente los años 2007-2016, se generaron más de 25.000 publicaciones científicas en el ámbito del cáncer, lo que sitúa a España en el top 10 mundial por número de publicaciones.
La bióloga molecular María Blasco, consiguió en 2008 rejuvenecer un ratón llamado Triple y evitar, por tanto, la aparición de enfermedades ligadas a la avanzada edad como el cáncer. El español Juan Carlos Izpisúa también consiguió rejuvenecer roedores. En el campo del tratamiento del cáncer destacan los trabajos del Dr. Jesús San Miguel y el Dr. Antoni Ribas . Los del Dr. Joan Massagué y la Dra. Soengas han conseguido identificar mecanismos por los cuales se originan tanto en el propio tumor como en el órgano en el cuál aparecerá la metástasis. El Dr. Elías Campo han participado en el proyecto internacional de secuenciación del genoma del cáncer.
Puntera en el corazón

La ciencia cardiovascular española tiene varios nombres propios. Valentín Fuster es uno de los cardiólogos más prestigiosos del mundo. Revolucionó las investigaciones en torno al síndrome coronario agudo, la primera causa de muerte en España. Premio Príncipe de Asturias de Investigación en 1996 por sus aportaciones en el campo de la biomedicina.
Los cardiólogos y hermanos Pere y Josep Brugada, detectaron la enfermedad de Brugada, una anormalidad electrocardiográfica en supervivientes de parada cardíaca.
Héroes de la Antártida

España conquista los hielos con la primera expedición, completada con éxito en 1982 a bordo de una goleta. Tras este primer hito, España ha destacado en la ciencia polar con la primera mujer española en participar en una expedición a la Antártida, Josefina Castellví. Además de contar con los buques de investigación Las Palmas (A-52) y Hespérides (A-33), y las bases Juan Carlos I –Isla Livingston, 1988– y Gabriel de Castilla –Isla Decepción, 1989-.
Los primeros de Atapuerca

En 1992 se descubren en la Sima de los Huesos de Atapuerca tres cráneos, entre ellos el mejor conservado del mundo, portada de Nature en 1993. Confirmaba la acumulación intencionada de restos de 28 individuos que vivieron durante el Pleistoceno medio. En 1994 aparecieron restos humanos en el nivel de TD6 de Gran Dolina, por debajo del evento Matuyama con más de 780.000 años de antigüedad, los restos más antiguos del continente europeo. Esta nueva especie bautizada como Homo antecessor.
En 1997 el Equipo de Investigación de Atapuerca recibió el Premio Príncipe de Asturias de Investigación Científica y Técnica.
España conquista las estrellas

¿Pedro Duque o Miguel López Alegría?. Además del eterno debate, España es una de las potencias espaciales dentro del programa espacial europeo de la ESA o de su contratista Airbus y otras instituciones. Canarias y Almería cuentan con observatorios astronómicos de referencia
Pedro Duque es el primer astronauta con nacionalidad española que viajó al espacio. La primera de sus dos misiones espaciales tuvo lugar en 1998 a bordo del transbordador espacial Discovery, dentro de la misión de la NASA STS-95. Este viaje duró 9 días y tuvo lugar en los meses de octubre y noviembre. La segunda vez en la que Pedro Duque estuvo en el espacio fue en 2003.
Miguel López-Alegría fue la primera persona nacida en España que estuvo en el espacio. Pero, viajó fuera de nuestro planeta con nacionalidad estadounidense. El primer español en el espacio nació en Madrid, en el año 1958, pero enseguida se trasladó a California. La primera misión fue en 1995, duró exactamente 15 días y 21 horas. El cosmonauta español formaba parte de la misión STS-73 de la Agencia Espacial Estadounidense. Volvió al espacio en el año 2000 y de nuevo en el 2002. La última de sus misiones espaciales tuvo lugar en 2006, cuando Miguel López Alegría viajó a la Estación Espacial Internacional.
La ciencia española, en femenino

España está, de hecho, entre los países de la Unión Europea con más mujeres investigadoras. Alemania, con 164.095, y España, con 85.759, ocupan la primera y segunda posición, respectivamente, en número de mujeres científicas. La proporción de mujeres en el conjunto del personal investigador en España es del 39%.
Nombres propios como los de Margarita Salas, Montserrat Calleja, Mariam Tortola, María Blasco, Celia Sánchez, María Josefa Yzuel o Paloma Domingo. Por primera vez, en 2017, fue nombrada una mujer presidenta del CSIC, Rosa Menéndez. Pero en el camino de la igualdad se interponen la fuga de talento o los problemas para compatibilizar la vida personal, familiar y profesional.
La 'armadura biónica'

El Consejo Superior de Investigaciones Científicas (CSIC) presentó el 8 de junio de 2016 el primer exoesqueleto del mundo dirigido a niños con atrofia muscular espinal (AME), una enfermedad que destruye la capacidad motora y que en España afecta a uno de cada 10.000 bebés.
El pequeño Álvaro, de cinco años edad, fue el primer niño de España con AME en probar el avance de forma experimental.
Bioimpresora 3D

En 2017, investigadores de varios centros y empresas, entre ellos la Universidad Carlos III de Madrid, presentaban un prototipo de bioimpresora 3D capaz de crear piel humana.
Esta nueva piel es uno de los primeros órganos humanos vivos creados por bioimpresión que llega al mercado y reproduce su estructura natural, con varias capas. El objetivo es que emplearla en trasplantes a pacientes con quemaduras y otros problemas en la piel.
Primer arte rupestre, en España

Una serie de nuevas dataciones, que retrasan hasta cerca de los 66.000 años la antigüedad de las pinturas de las cuevas de Ardales (Málaga), Maltravieso (Cáceres) y La Pasiega (Cantabria), atribuyen su autoría a los neandertales y las convierten en las más antiguas conocidas hasta el momento en el mundo.
Un equipo multidisciplinar de catorce expertos, asociados a distintas instituciones científicas como las universidades españolas de Alcalá, Barcelona, Isabel I (Burgos) y Cádiz, dio a conocer este descubrimiento en Science en 2018.
Avances españoles contra el VIH

Menos del 1 % de las personas infectadas con el virus del sida jamás desarrolla la enfermedad. Hasta este año la causa era un misterio, pero científicos del Instituto de Salud Carlos III, la Universidad de La Laguna de Tenerife y el Instituto de Investigación del Sida IrsiCaixa de Barcelona señalaron por primera vez al responsable: proteínas defectuosas en la envoltura del microorganismo. Este no fue el único avance en el estudio del VIH de 2019 con contribución española. Un estudio de la Universidad Rockefeller (Nueva York, EE UU), cuya primera autora fue la española Pilar Mendoza, propuso un tratamiento alternativo a los retrovirales actuales con menos efectos secundarios.









